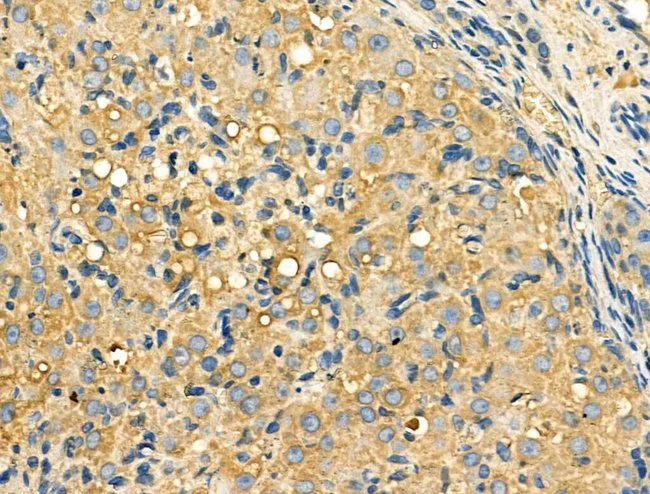

WB analysis of HepG2 cell lysate using GTX03644 Galectin 9 antibody. The lane on the left was treated with the antigen-specific peptide.
Galectin 9 antibody
GTX03644
ApplicationsWestern Blot, ImmunoHistoChemistry, ImmunoHistoChemistry Paraffin
Product group Antibodies
ReactivityHuman, Rat
TargetLGALS9
Overview
- SupplierGeneTex
- Product NameGalectin 9 antibody
- Delivery Days Customer9
- Application Supplier NoteWB: 1:500-1:2000. IHC-P: 1:50-1:200. *Optimal dilutions/concentrations should be determined by the researcher.Not tested in other applications.
- ApplicationsWestern Blot, ImmunoHistoChemistry, ImmunoHistoChemistry Paraffin
- CertificationResearch Use Only
- ClonalityPolyclonal
- Concentration1 mg/ml
- ConjugateUnconjugated
- Gene ID3965
- Target nameLGALS9
- Target descriptiongalectin 9
- Target synonymsHUAT, LGALS9A, galectin-9, ecalectin, gal-9, lectin, galactoside-binding, soluble, 9, tumor antigen HOM-HD-21, urate transporter/channel protein
- HostRabbit
- IsotypeIgG
- Protein IDO00182
- Protein NameGalectin-9
- Scientific DescriptionThe galectins are a family of beta-galactoside-binding proteins implicated in modulating cell-cell and cell-matrix interactions. The protein encoded by this gene is an S-type lectin. It is overexpressed in Hodgkins disease tissue and might participate in the interaction between the H&RS cells with their surrounding cells and might thus play a role in the pathogenesis of this disease and/or its associated immunodeficiency. Multiple alternatively spliced transcript variants have been found for this gene. [provided by RefSeq, Jul 2008]
- ReactivityHuman, Rat
- Storage Instruction-20°C or -80°C,2°C to 8°C
- UNSPSC41116161